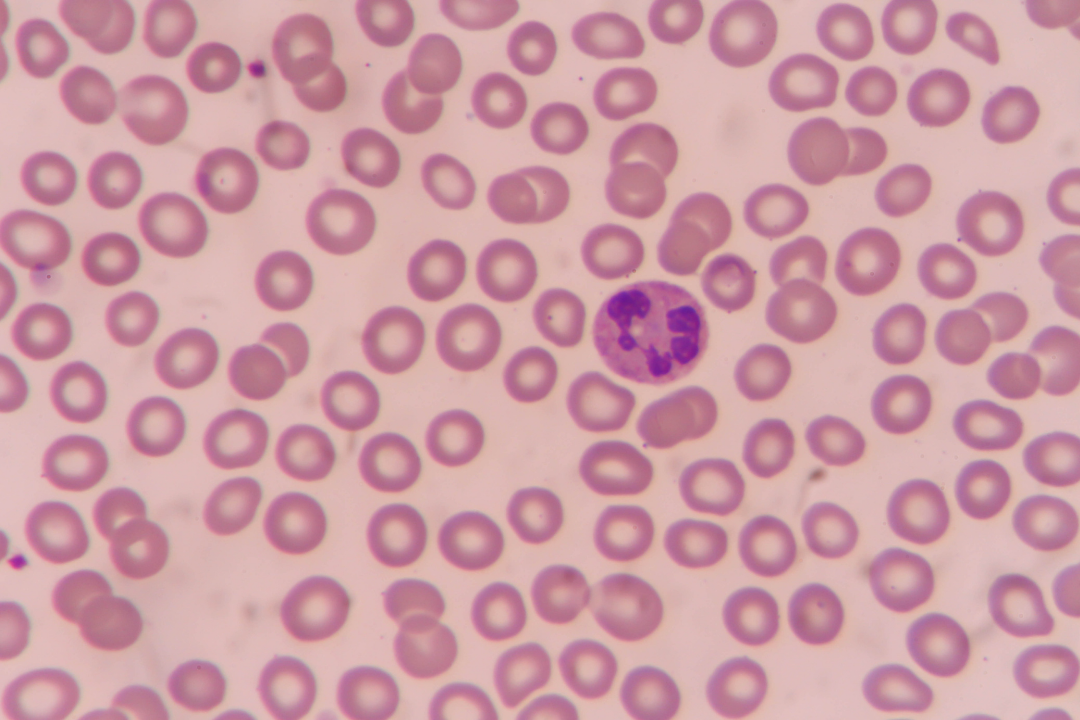
Les neutrophiles, cellules essentielles pour le traitement des pneumonies par immunothérapie innovante

En ce début d’année, nous tenions à vous remercier.
Votre soutien sans faille permet de faire de notre campus lillois un espace de recherche unique en France, où 30 équipes travaillent à la lutte contre des pathologies majeures telles que les maladies infectieuses (COVID-19, tuberculose, coqueluche), les cancers, les maladies neurodégénératives comme Alzheimer, les maladies cardiovasculaires, ou encore métaboliques comme le diabète ou l’obésité…
Au total, ce sont 800 professionnels de 30 nationalités qui – grâce à votre soutien – œuvrent chaque jour pour permettre à chaque être humain, à travers le monde, de vivre mieux plus longtemps. Alors du fond du cœur, merci !
En 2025, grâce à vous, nous poursuivrons plus que jamais notre engagement envers la recherche médicale et la prévention en santé.
Parce que nos travaux de recherche et de prévention s’effectuent chaque jour au plus près de vous, nous avons voulu vous donner la parole en ce début d’année. Nous sommes partis à la rencontre des Lillois et des Lilloises et les avons interrogés sur LEUR vision de la santé, leurs habitudes de prévention, et leurs espoirs envers la recherche médicale de demain.
Bon visionnage !